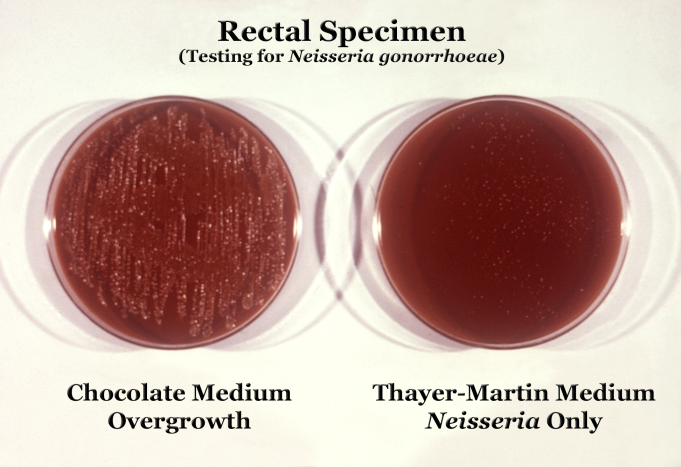
Гонорея — що це, причини, симптоми, лікування | Блог | Complimed

Що таке Гонорея?
Гонорея. Кому-то це слово вже знайоме, а хтось почує вперше. Але знаємо одне — ігнорувати не можна. Що ж це таке — гонорея? Інфекційна хвороба, яка передається статевим шляхом. Проблема серйозна, яка вимагає уваги венеролога.
Симптоми гонореї
Почнемо з класики: симптоми. Не завжди очевидні. А інколи такі, що тільки з ногами прогулятись до лікаря. Основні признаки включають:
- Виділення з сечостатевих органів
- Біль або печіння при сечовипусканні
- Свербіж і дискомфорт
- Запалення горла у випадку орального контакту

Та ось підвох: у жінок це все може проскочити безсимптомно. І навіть не задумуються — хочуть просто жити далі.
Шляхи передачі
Передавачі гонореї надзвичайно винахідливі. Зустрічались статево з кимось ризикованим? І через оральні, вагінальні, або анальні статеві контакти ота зараза ледь не автоматом вітається з новою жертвою. Значить, все серйозніше, ніж здається.
Діагностика гонореї
А ось тут без ретельного тестування ніяк. Навіть не думай на око визначати. Адже є методи перевірки: бактеріологічні, ПЛР, а у разі чого — тест на антибіотикорезистентність. Без лабораторії важко, правда ж?
Лікування гонореї
Гонорея — не вирок! Тому, якщо у тебе діагностували цю неприємність, мотай собі на ус, що лікоть вже поруч. Антибіотики стануть на твоєму боці. Іноді курс одного препарата, інколи комбінація. Якщо ж запущено, то святкуй знайомство з тривалішим курсом. І, до речі, без самолікування — чули? Це не те, де варто халатно вирішувати самому.
Ускладнення
Щодо ускладнень… Ну, звісно ж, таке не пройде безболісно. Нелікування загрожує запальними процесами органів малого тазу, які чують своє маленьке: “Привіт, безпліддя!”. Небезпека триває і для чоловіків: простатит, запалення придатків яєчка. І як вам таке задоволення?
Попередження
Навіщо воювати з тим, чого можна і уникнути, чи не так? Ось кілька простих рекомендацій:
- Використання бар’єрних методів контрацепції
- Регулярні статеві перевірки
- Дотримувати особисту гігієну
- Обмежити кількість статевих партнерів
Завершення розмови
Отож, гуляючи Києвом або десь іншим ранком або ввечері — пам’ятайте про те, що ми обговорили. Не хай буде одним із тих випадків “коли я знав, але не зробив”. Не варто ігнорувати здоров’я. Адже воно одне.








